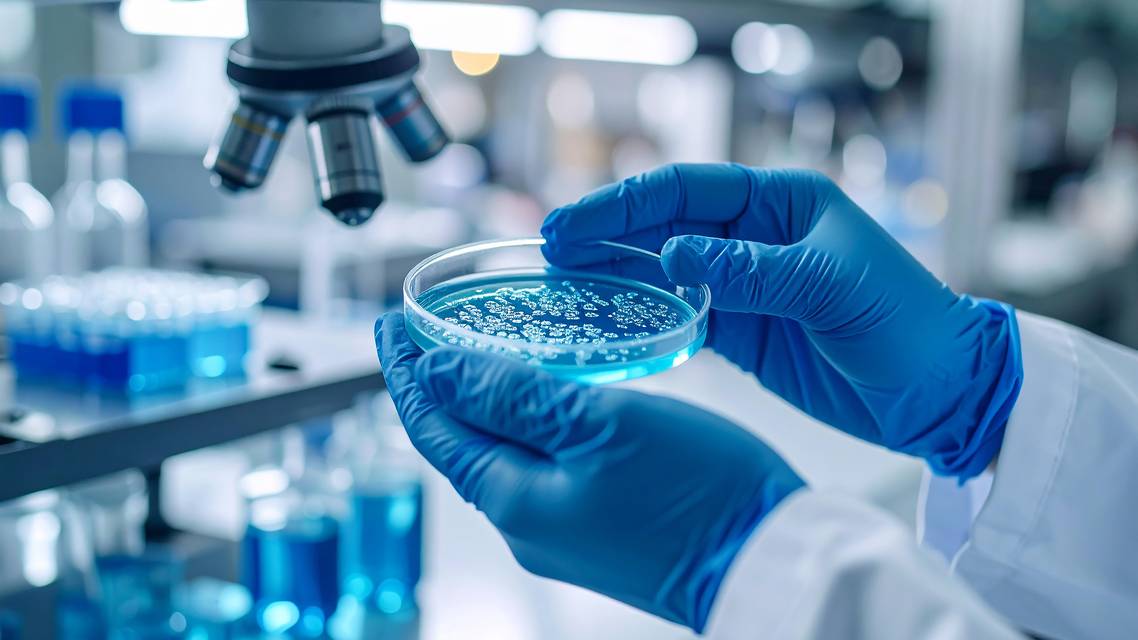
aesthetic medicine

Board Forum: Hope and Skepticism in the Aesthetics Pipeline
What latest scientific advancements currently available in aesthetics are you most excited by? Which are you most skeptical of?
Jason Pozner, MD: I am excited by the potential for micro-coring and waiting to see the latest devices.
Julie Woodward, MD: I’m skeptical about micro-coring because we haven’t heard much about it since the initial market release.
I am looking forward to new advances in injectables from pre-filled toxin syringes to new biostimulators. And more launches for under-eye filler.
Jeanine Downie, MD: Lately, I am very excited with the skin tightening devices like the new Zaffiro by Neauvia. This device is good for all skin types/races/ethnicities and tightens the face, the neck, and all over the body down to the legs!
Additionally, I am very interested in learning more about the Resonic device with the rapid acoustic pulse technology for cellulite treatment and how that might work in combination with Qwo.
I am very skeptical of most devices that say they can tighten the lower and upper eyelids.
Steven J. Pearlman, MD: There are so many skincare options and new ingredients, but which are really better, which are not as good, which don’t make a difference?
For hair, do oral supplements really work, do you need to do topicals along with injections, PRP/PRF vs exosomes, who are the patients most likely to respond to these treatments and who isn’t?
I would like to see more data for anti-aging devices (lasers, RF, RF microneedling, threads, MyEllevate). What percent improvement do you really see and how long do these really last vs. surgery? For threads, most studies or before and afters are at a few weeks to 3 months. I’d like to see 1 year and not selected patients, but sequential patients.
Joel Schlessinger, MD: JAK inhibitors for both vitiligo and alopecia areata are incredibly exciting for me. We participated in many of the JAK inhibitor trials and the results were remarkable in many of the patients, some of whom had given up hope of ever finding a cure or improvement.
I am skeptical of many of the newer lasers until I see actual proven results when they are in clinical use, having been “burned” on several occasions by lasers that didn’t live up to their theoretical and marketed claims.
Gregory Buford, MD: I am really excited, but at the same time skeptical, about the rise in use of biologics in the aesthetic medicine space. Whether it is PRP, stem cells, or exosomes, we are hearing a ton of buzz about the regenerative properties of these compounds. But for the most part, the proof is mostly anecdotal (at best) and could benefit from more rigorous trials.
There is potential here but we just need to evaluate more closely what these substances can do as well as what they can’t do and evaluate them with a more refined approach.
Thinking about the aesthetic pipeline, what are you most looking forward to moving from bench to clinic in the next 3 to 5 years?
Dr. Schlessinger: There are several new toxins in the pipeline that could offer a more stable, easier experience for both the clinician and the patient. Fillers are being developed that could offer advantages in longevity without some of the risks of the longer-acting fillers, as well.
Dr. Pearlman: I’m always looking for newer and better fillers, new devices. Of course, daxibotulinum toxin.
Dr. Downie: Looking at the aesthetic pipeline, there is a clinical trial I will hopefully get involved with involving large volumes of non-invasive fat melting that I am very excited about!
Dr. Buford: I see biologics as the new age of aesthetic medicine and am excited to see what lies ahead in the next few years. For the most part, we currently rely on products that are static and less interactive with tissue. The next stage will inevitably be products that dynamically improve tissue and regenerate in an active manner.
Ready to Claim Your Credits?
You have attempts to pass this post-test. Take your time and review carefully before submitting.
Good luck!
Recommended
- Practice Development
Rising Popularity of MedSpas Brings Increased Scrutiny Nationwide
Brandon Zarsky, Esq.; Guillermo J. Beades, Esq.Brandon Zarsky, Esq.; Guillermo J. Beades, Esq. - Practice Development
How Generation X Is Shaping Aesthetic Practice Strategies of the Future
Jeanine Downie, MD, FAADJeanine Downie, MD, FAAD